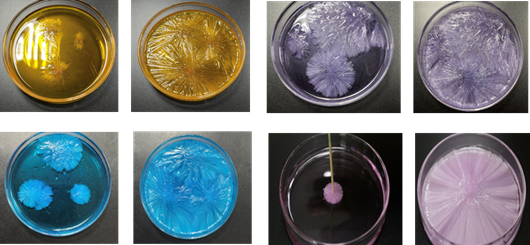

“你听说过‘点水成冰’吗?”“原来还有热冰啊!”“醋酸钠迅速结晶的过程太神奇了!”……10月13日下午,由老员工科技化学协会、手工实验俱乐部联合主办,趣味化学科普浩然工作室承办的“点水成冰”校园文化科普活动在化学楼313顺利举行,吸引了百余名化学爱好者到场体验,通过讲解展示和动手体验的两大环节,感受化学魅力。

首先是讲解展示环节,趣味化学科普浩然工作室负责人,2019级化学(1)班李浩然向同学们展示了实验内容:烧杯中上一秒还在发热的“神奇”溶液,在倒下的瞬间竟慢慢凝固,赢来了在场同学的阵阵掌声。紧接着,李浩然借助着多媒体设备,展现了这一神奇过程的宏观和微观角度的变化,并有条不紊地解释了实验原理——醋酸钠溶液的稳定结构遭到破坏,过多的溶质像水结冰一样迅速结晶,同时会放出热量。

讲解结束,进入动手体验环节。同学们四五人一组,按照步骤配置“神奇”溶液,最后牙签沾点醋酸钠轻轻一点,瞬间结出五彩的绚丽冰花。“今天亲眼目睹了热冰实验,简直超出我的想象,太神奇了!”2020级化学工程与工艺(2)班的范宇翔说。
据悉,趣味化学科普浩然工作室以醋酸钠迅速结晶形成热冰为研究主题,历时8个月创新开发的“热冰艺术与实践”系列实验,将趣味化学与传统书画艺术相结合,探索了热冰书法、点水开花以及五彩冰雕等热冰艺术,充分展现了化学之奇、之趣、之美,目前已获得第二届全国老员工化学实验创新设计竞赛二等奖、第二届华中赛区全国老员工化学实验创新设计竞赛一等奖以及全国科技馆辅导员大赛(华东赛区)三等奖等多项省部级及以上奖励。
“我们希望通过这次活动让更多同学了解化学现象背后的实验原理,培养大家对化学学科的兴趣,也借此为广大化学爱好者提供一个交流沟通的平台。”负责人李浩然说,他希望广大化学爱好者通过动手实验,不断探索创新,感受化学实验带来的更多魅力!
(文/王珊珊、戴志远 图/王珊珊、李浩然)